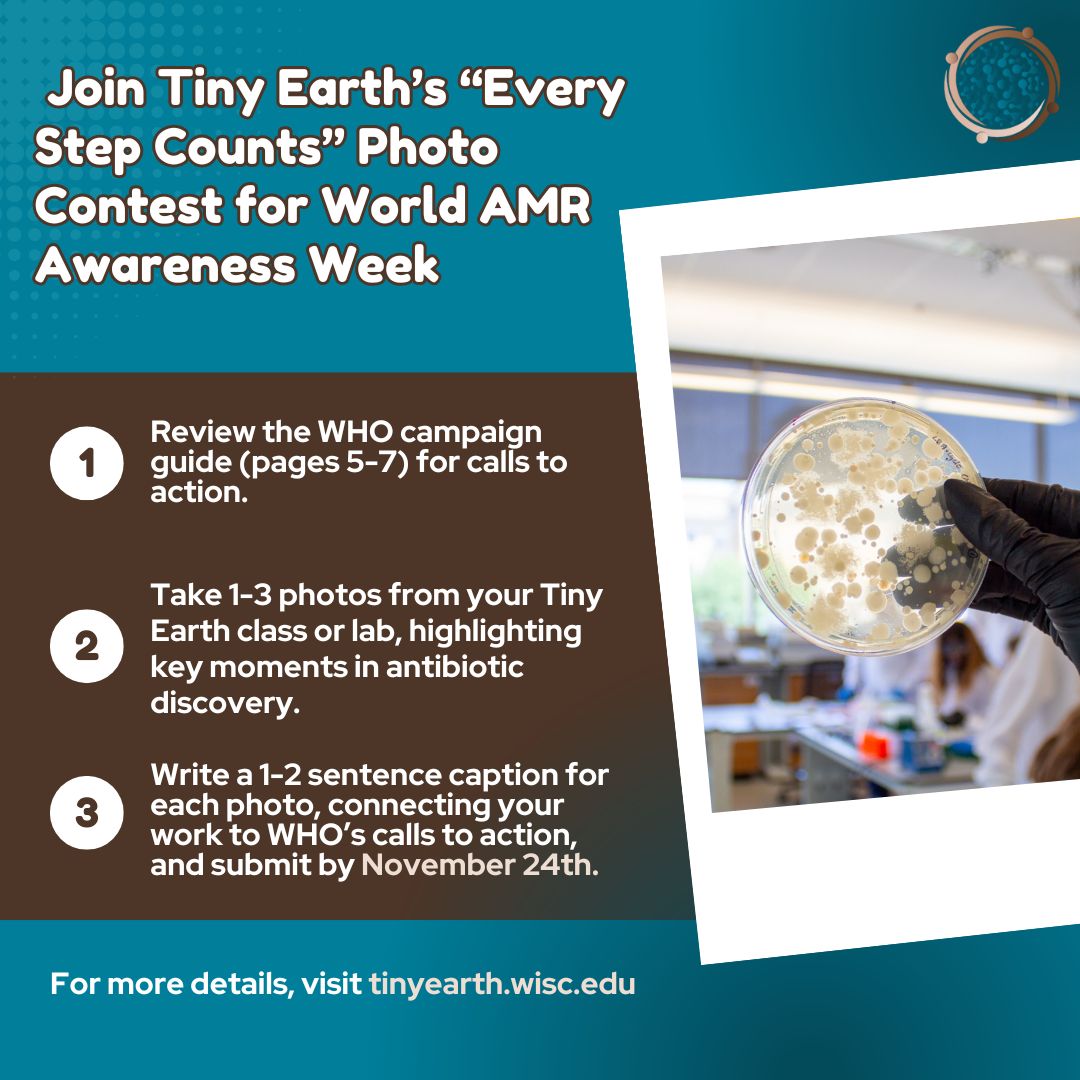

Tiny Earth
@tinyearthnet
Our network is studentsourcing antibiotic discovery through an inspiring and innovative science curriculum. HQ at @WIDiscovery @UWMadison.
ID: 959115021824520196
http://tinyearth.wisc.edu 01-02-2018 17:23:35
680 Tweet
1,1K Followers
335 Following







Searching for antibiotic producing microbes in the soil as part of intro biology at Univ. of Puget Sound! Tiny Earth ASM



Professor Betsy Martinez-Vaz’ #Microbiology class examines bacteria collected from soil from around campus in an effort to help create new antibiotics as part of Tiny Earth. Learn more about Hamline’s biology department: bit.ly/_Hamline_Biolo…

Tiny Earth had a blast at the Science Expeditions Campus Open House (science.wisc.edu) this past weekend! Visitors got to identify soil by feel, view soil (including bacteria!) under a microscope, and take a look at antimicrobial resistance from plates with bacterial growth.